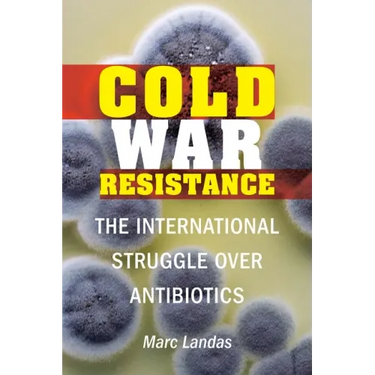
Cold War Resistance: The International Struggle Over Antibiotics

Cold War Resistance: The International Struggle Over Antibiotics - Hardcover
Cold War Resistance: The International Struggle Over Antibiotics - Hardcover
$46.95
/

Your payment information is processed securely. We do not store credit card details nor have access to your credit card information.
by Marc Landas (Author)
In June 1941 a pair of British scientists boarded a plane for America with World War II raging all around them. They carried a precious commodity--penicillin--and the knowledge that it would change history. Once the U.S. government had been debriefed, the Office of Science Research and Development, in conjunction with British counterparts, assumed control, and penicillin became a top-secret matter of national security, second in importance only to the atomic bomb.
In Cold War Resistance Marc Landas uncovers the dark history behind the discovery, production, and distribution of penicillin and other antibiotics. In 1949 the United States embargoed any material deemed of "strategic importance," including antibiotics, from going to Communist countries, effectively shutting off the Soviet Union from a modern medical miracle. The Soviets responded by creating satellite antibiotic factories in Warsaw Pact countries that produced subpar antibiotics, which soon led to antibiotic resistance. Today, the number of effective antibiotics available is dwindling, and the state of antibiotic resistance is worsening. The Cold War played a critical role in fostering this resistance, as Landas argues in this pathbreaking history of the international struggle over antibiotics.Author Biography
Marc Landas is an editor at Scientific Inquirer and freelance writer. He is the author of The Fallen: A True Story of American POWs and Japanese Wartime Atrocities.